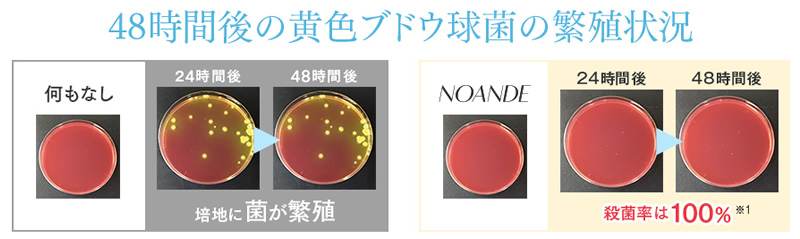

NOANDE(ノアンデ)とは?
わきがの原因菌を100%殺菌し、効果をすみずみまでカバーするように、有効成分を2倍、浸透力も2倍にした相乗効果で「わきが」を抑制するのがノアンデなのです。
ここがオススメ
デオドラントケアでお悩みの方に!ノアンデは新しいコンセプトの「わきが」対策をお届けします。

新開発のトリプル製法でさらにパワーアップしたノアンデ!
わきが、すそわきがで悩んでいるアナタ…ノアンデをぜひ試してみてください!
ノアンデは原料が天然素材で添加物は使用していません。だからデリケートゾーンにも安心して使えるのです。
また浸透力を高めたことで汗にも強くなり、何度も塗り直す必要がないのです。もう何度もニオイ気にすることはありません。
わきがの原因菌を100%殺菌!
ノアンデは、わきが菌の原因の一種である黄色ブドウ球菌への抑制実験で100%の殺菌を実現。ニオイの原因から取り除きます。
※わきが菌の原因の一種である黄色ブドウ球菌への抑制実験です。人に対して効果を保証するものではありません。
すみずみまでしっかりとカバーして効果が持続する!

浸透力を2倍に高めたノアンデは、すみずみまでしっかりとカバーしてニオイを抑制します。また汗にも強く効果が長時間持続するので、頻繁に気にする必要がなくなります。
無着色・無香料で添加物は含まれていません!
ノアンデは、天然由来の原料から製造された無添加のデオドラントケア製品です。敏感肌や乾燥肌の方などにも安心して使っていただけます。

無期限の全額永久返金保証!ってホント?!

ノアンデはよほど効果に自信があるのでしょう。それで無期限の全額永久返金保証のサポートがあります。
但し、これには条件があって無期限なのは定期コースのユーザーで一世帯につき初回の1本分が対象ということになっています。
単品の購入の場合は購入後30日間になります。
何回でも返金されるわけではないのですが、効果は最初の1回で分かるはずですから問題ないでしょう。
多くのメディアに取り上げられた話題の商品です!
全く新しい「わきが」対策のコンセプトが雑誌などに取り上げられて注目されているのが「ノアンデ」なのです。

商品詳細・ご購入
お買い求めは定期コースがお得です。

